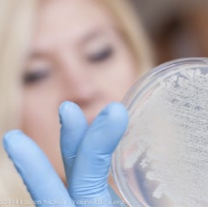
Anne_Plate

What people are saying:
“Whether brewing better beer, discovering novel antibiotics or chronicling the lives of the microscopic creatures living in the dust under the couch, Anne Madden seeks to understand and utilize the microbial world around us.” – TED.com
“Anne Madden sees the beauty and brawn of creepy-crawly microbes and how they may hold the solution to many human problems.” – The Scientist, December 13, 2024
“Dr. Anne A. Madden wears many hats. Some of them are physical, like the statement hats with 3D-printed microbes she wears as science conversation starters. Some are metaphorical, like her shared roles as an industry scientist, academic researcher, and science communicator.” – SMORE Science Magazine, March 15, 2020
“Anne Madden bends creatures to her will, with the deftness of a shepherd. But Madden is a microbe wrangler — her critters cover petri dishes. Rather than merely observe bacteria and fungi, Madden sees a community ready for work.” – PBS NewsHour, June 16, 2017
“Your dust bunnies, it seems, have some stories to tell. By examining the DNA in dust, researchers have shown that we share our houses with a legion of mysterious creatures. And they’ve created the first map showing their range across the US.” — Newsweek, November 22, 2016
“These days, her experiments are buzzing, as she takes microbes—yeast—from bees and convinces them to brew beer.” – Scientific American June 26, 2017
Project: An animal behavior and synthetic systems engineering project
Client: MIT Media Labs – The Synthetic Apiary Project
Architect Magazine, de zeen, Fast Company, Arch Daily, Financial Times.
Project: An interdisciplinary science engagement and marketing campaign
Client: Thermo Fisher Scientific – The DIY Gingerbread Marketing Campaign
Project: A DNA sequencing service
Client: The Best Bees Company – HoneyDNA Product Line
Improper Bostonian, National Geographic (01/2018 print, 02/2018 online), featured in a TEDx talk by Noah Wilson-Rich available at TED.com, and at Boston’s Hubweek.
Project: The first continental-scale analysis of arthropods in homes via eDNA methods
Research from University of Colorado Postdoc: Arthropods in Your Home – From a Swab of Dust
Newsweek (online and print), CBS News, The Washington Post, Chicago Tribune, and Scientific American, Northern Woodlands.
Project: Microbial discovery pipelines for new yeasts from insects
Research from North Carolina State University Postdoc, and Lachancea LLC: Novel Yeasts for the Food, Beverages, and Biofuel Industries
Interview with the ‘beer team’ and me about fungi, our novel beers, and the awesomeness of the microbial world, within the larger documentary “The Kingdom” produced by Smith&Nasht.
The Wall Street Journal, National Geographic (The Plate), Discovery Channel, News&Observer, PBS-NOVA, PBS News Hour, FoodandWine(FWx), Indy Week, North Carolina Public Radio (WUNC), All About Beer Magazine, Paste Magazine, Raleigh & Company, CBS WNCN, Vice Magazine, Loaded Magazine, Interesting Engineering, NPR, Scientific American, The Daily Beast, October Magazine.
Research: Sourdough Microbiology
The Atlantic, Gastropod podcast, Bon Appetit Blog, The Microbial Menagerie, The BBC, Civil Eats, UNC-TV, The New York Times, Verve Magazine (Indian Lifestyle Magazine), Vice, NPR All Things Considered, VPM NPR/PBS, C&EN, The Guardian, Atlas Obscura, CNN, Smithsonian Magazine, Martha Stewart, Inverse, The Counter, National Geographic.
Personal Press
SMORE science magazine
Interview, Cover feature (April, 2020)
River of Suck, Podcast
Interview (December, 2019)
The Joyful Microbe, Blog
Interview (November, 2019)
The Disruptors, Podcast
(October, 2019)
Wellesley College Magazine
Interview, Cover feature (May, 2019)
The Native Society
Interview (April, 2018)
Canadian Broadcasting Company: The Current
Interview (April, 2018)
She Does the City
Interview (April, 2018)
Phi Beta Kappa: The Key Reporter
Interview (March, 2018)
DT Next
Interview (January, 2018)
The Heroine Collective
Interview (November, 2017)
Micrographia Today
Cover interview (April, 2015)
Improbable Research
“2015 LFHCfS Woman of the Year” (January, 2015)
YourWildLife.org
“Before they were Scientists” Interview. (October, 2014)
Tufts Alma Matters
“Game-Changing Grants” Interview. (Fall, 2010)
Research: Novel Fungus from a Wasp Nest
Science Friday – Talking Science
“Discovering a New Fungus” (December, 2011)
Medicine Health News Medsante
E! Science News
Science Newsline
Science News Daily
Wild Biology
Sci Guru Science News
“Scientists Find a New Species of Fungus in a Wasp Nest” (November, 2011)
The Tufts Daily
“The Secret Life of Wasps” (November, 2011)
Tufts Now
“A New Fungus Among Us” (November, 2011)
Dr. Madden quotes in the press
Science (January 18, 2016) Re: Research on wasps and yeasts
New Scientist (January 18, 2016) Re: Research on home arthropods

**((Photo credits are Alonso Nichols/Tufts University, AAM, Lauren Nichols/YourWildLife.org, AAM. Photos can only be used with permission))**